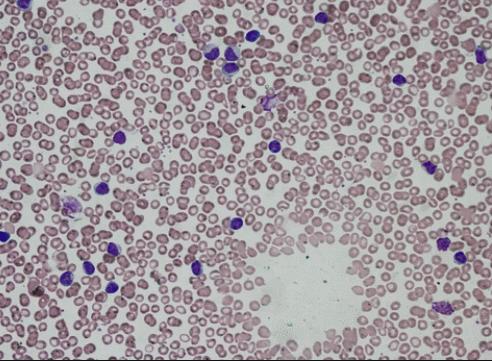
再生医学日本,日本再生医学治疗肾最新进展

撰文:江南大学 墨忆
专家审核:江苏大学附属医院 李晶 教授
随着再生医学的发展,越来越多的医疗专家将目光转向了皮肤再生医学,尤其是在面部和颈部,以解决面部衰老和皮肤伤口愈合问题。皮肤再生医学分为基于细胞治疗和无细胞治疗,根据近期发表的综述 [1],目前基于细胞治疗的皮肤再生医学在日本已经兴起了大量的临床应用,并被证实是安全有效的。
01 基于间充质干细胞的皮肤再生医学
间充质干细胞是一种成体干细胞,可以从各种组织中分离出来,并用于皮肤治疗和美容的应用研究当中。
1) 脂肪间充质干细胞(AD–MSCs)
实验研究表明,脂肪间充质干细胞可以有效改善衰老皮肤。2015年,科研人员[2]在临床试验中对6名年龄在45-65岁的患者使用了AD-MSCs进行面部提拉,并在临床试验中报告了面部提拉恢复的效果。在临床试验中,使用透明质酸作为AD-MSCs在组织修复中的载体,在改善皮肤皱纹方面具有很好的效果。

同时,在日本厚生劳动省和日本再生医疗学会等的监管下,一些基于干细胞的临床研究正在进行中,其中包括基于AD-MSCs的皮肤病治疗,如皱纹和弹性丧失,这类治疗通常在再生医学风险分类的II级和III级皮肤科或美容外科诊所实施。
2) 骨髓间充质干细胞(BM-MSCs)
越来越多使用BM-MSCs治疗的皮肤再生疾病的临床研究已经完成或仍在进行中,包括光老化、硬皮病、大疱性表皮松解症、特应性皮炎和糖尿病性皮肤溃疡。
在日本,骨髓间充质干细胞作为一种基于细胞和组织的产品,已获得MHLW的批准。例如,JCR Pharmaceuticals Co.,Ltd.有限公司销售的一种人类(自体)骨髓衍生MSC,用于治疗儿童和成人的急性移植物抗宿主病(aGvHD)[3]。aGVHD主要针对临床表现为瘙痒或疼痛的斑丘疹的皮肤,最初在急性期累及颈背、耳朵、肩膀、手掌和脚底,然后扩散到整个表皮,最终融合。在严重的移植物抗宿主病中,斑丘疹形成大疱性病变,伴有类似史蒂文斯-约翰逊综合征的毒性表皮坏死。

3)脐带间充质干细胞(UC-MSCs)
与其他MSC类似,一项针对银屑病患者的UC-MSCs治疗的临床研究(NCT03765957)证实了UC-MSCs疗法是一种安全的皮肤治疗方法。
此外,2021年韩国的一个研究小组报告了一名47岁长期顽固性银屑病男性患者,通过使用UC-MSCs疗法得到了成功的治疗[4]。

图A和B:UC-MSCs第一次移植后第15天(A)和第122天(B)观察到的双手和手腕的红斑变化[4]
02 使用成纤维细胞治疗皮肤疾病
成纤维细胞是合成胶原蛋白和其他细胞外基质(ECM)蛋白的主要结缔组织细胞,成纤维细胞移植可以促进ECM的合成并改善皮肤皱纹。
Epicel使用培养的表皮角质形成细胞,是最早成功的基于细胞的结构修复疗法[5]。Epicel是一种由健康皮肤生长而成的皮肤移植物,为皮肤烧伤患者提供皮肤替代品,并被美国食品药品监督管理局(FDA)批准为“人道主义使用设备”。Epicel目前由Vericel公司在美国生产和销售。

另一款产品是Apligraf,于1998年获得美国食品药品监督管理局批准用于治疗腿部静脉溃疡,2000年批准用于治疗糖尿病足溃疡[6]。Apligraf是一种生物工程同种异体皮肤替代品,用于治疗腿部静脉溃疡和糖尿病足溃疡。Apligraf是通过在牛I型胶原基质中培养人包皮衍生的新生儿成纤维细胞来构建的,随后在牛Ⅰ型胶原基质上培养人包皮来源的新生儿表皮角质形成细胞。
在日本,使用成纤维细胞治疗皮肤衰老已被批准为II类再生医学风险[7]。首先,采集患者耳廓后面的皮肤,分离并培养成纤维细胞,然后将其移植回同一患者。

在美国,Isolagen的自体成纤维细胞产品(商品名:LAVIV®)于2001年获得美国食品药品监督管理局的批准,该产品的生产目的是改善成年人的鼻唇沟。此外,LAVIV®被证明可以有效改善*疮痤**疤痕[8]。
03 使用黑素细胞治疗皮肤疾病
表皮从外表面开始,由颗粒层、棘层和基底层组成,基底层包含产生黑色素的黑色素细胞。在日本,自体表皮移植被归类为II类再生医学风险分类。
白癜风是一种黑色素细胞消失或减少,导致色素损失和皮肤变白的疾病。目前白癜风确切的患病率尚不清楚,但据报道发病率为1/2000。白癜风的治疗包括局部类固醇和免疫*制剂抑**结合光疗。然而,这种治疗方法对一些患者来说是不够的,这些患者可以采取自体表皮移植进行治疗。
然而,没有培养的表皮移植需要从受白癜风影响的同一位置周围的正常皮肤组织中收集表皮,从而限制了可以移植的皮肤数量。相比之下,在自体表皮移植中使用培养扩增技术有利于移植到大的白癜风影响区域,即使皮肤收集区域很小。在收集并培养患者的表皮后,将片状培养的表皮移植到白癜风患者的患处。移植后,黑色素细胞在该区域产生黑色素[9]。这有助于恢复受影响区域的皮肤颜色。
04 基于细胞外泌体的皮肤再生医学
MSC衍生的细胞外囊泡/外泌体通过修饰受体细胞中的基因表达和蛋白质产生,表现出与MSC相似的组织修复效果。此外,新出现的证据表明,MSC衍生的外泌体在伤口愈合过程中增加了皮肤细胞的增殖和迁移,并抑制了细胞凋亡。

2019年,山东大学的一项研究证明[10],来源于脂肪组织的MSCs条件培养基通过增加水合作用和皮肤弹性、更高浓度的真皮胶原和更高的弹性蛋白密度,有效治疗13名萎缩性*疮痤**疤痕患者。由于其能够释放不同的生长因子,包括碱性成纤维细胞生长因子(bFGF)、KGF、TGF-β1、HGF和VEGF,脂肪组织的MSCs来源的外泌体可以通过增加真皮胶原的产生和成纤维细胞迁移到真皮中来消除皱纹和改善面部缺陷。
随着再生医学的逐渐发展,皮肤损伤和皮肤老化已经逐渐得到改善,再生医学的产品有望在未来提供相对安全、更有效的皮肤再生治疗选择。相信在不久的未来,基于细胞疗法的可再生医学会逐渐走向大众,造福大众!
[1] Current regenerative medicine-based approaches for skin regeneration: A review of literature and a report on clinical applications in Japan
https://www.sciencedirect.com/science/article/pii/S2352320422000517
[2] Antiaging treatment of the facial skin by fat graft and adipose-derived stem cells
https://journals.lww.com/plasreconsurg/Abstract/2015/04000/Antiaging_Treatment_of_the_Facial_Skin_by_Fat.11.aspx
[3] Regenerative medicine and gene therapy in Japan.
https://www.pmda.go.jp/files/000241234.pdf
[4] Psoriasis treatment using minimally manipulated umbilical cord-derived mesenchymal stem cells: a case report
https://www.wjgnet.com/2307-8960/full/v9/i23/6798.htm
[5] Fundamentals of cell-based therapies
https://www.sciencedirect.com/science/article/pii/B9780123694102500048
[6] Medical products from stem cells
https://www.sciencedirect.com/science/article/pii/B9780128239667000086
[7] New Japanese initiatives on stem cell therapies
https://pdf.sciencedirectassets.com/274143/1-s2.0-S1934590914X00160/1-s2.0-S193459091500123X/main.pdf
[8] Successful treatment of depressed, distensible acne scars using autologous fibroblasts: a multi-site, prospective, double blind, placebo-controlled clinical trial
https://com-mendeley-prod-publicsharing-pdfstore.s3.eu-west-1.amazonaws.com/dbb5-PUBMED/10.1111/dsu.12204/dsu0039_1226_pdf.
[9] Cultured epidermal melanocyte transplantation in vitiligo: a review article
http://mr.crossref.org/iPage?doi=10.18502%2Fijph.v48i3.881
[10] Fetal dermal mesenchymal stem cell-derived exosomes accelerate cutaneous wound healing by activating Notch signaling
https://com-mendeley-prod-publicsharing-pdfstore.s3.eu-west-1.amazonaws.com/dcf3-PUBMED/10.1155/2019/2402916/SCI2019_2402916_pdf.
本文为知识性科普,仅供学习、交流,请勿用作商业用途。